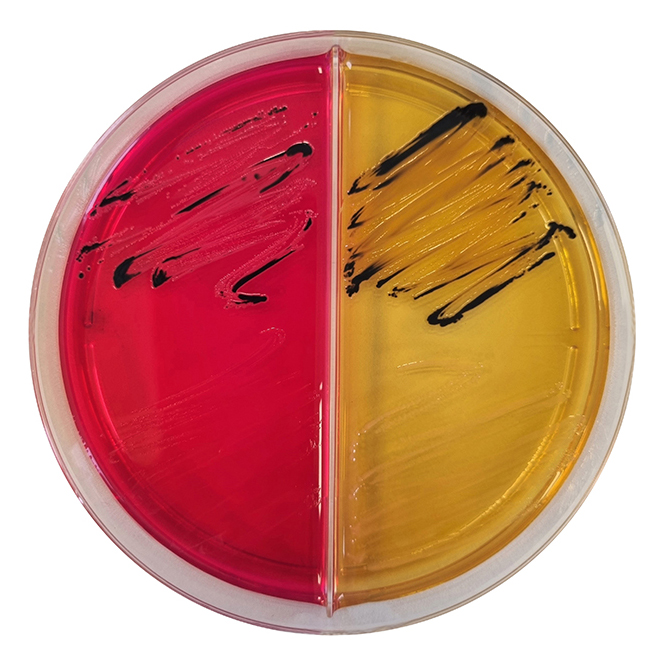

Über das Produkt
Fertigplatten zur Detektion und Isolierung Gram-negativer darmpathogener Erreger, insbesondere Shigella spp. und Salmonella spp. aus klinischen Proben und anderem Probenmaterial.
Produkte
Mikrobiologie
Fertigplatten
Salmonella-Shigella-Agar / XLD-Agar, geteilte Fertigplatten
Salmonella-Shigella-Agar / XLD-Agar, geteilte Fertigplatten
Fertigplatten zur Detektion und Isolierung Gram-negativer darmpathogener Erreger, insbesondere Shigella spp. und Salmonella spp. aus klinischen Proben und anderem Probenmaterial.